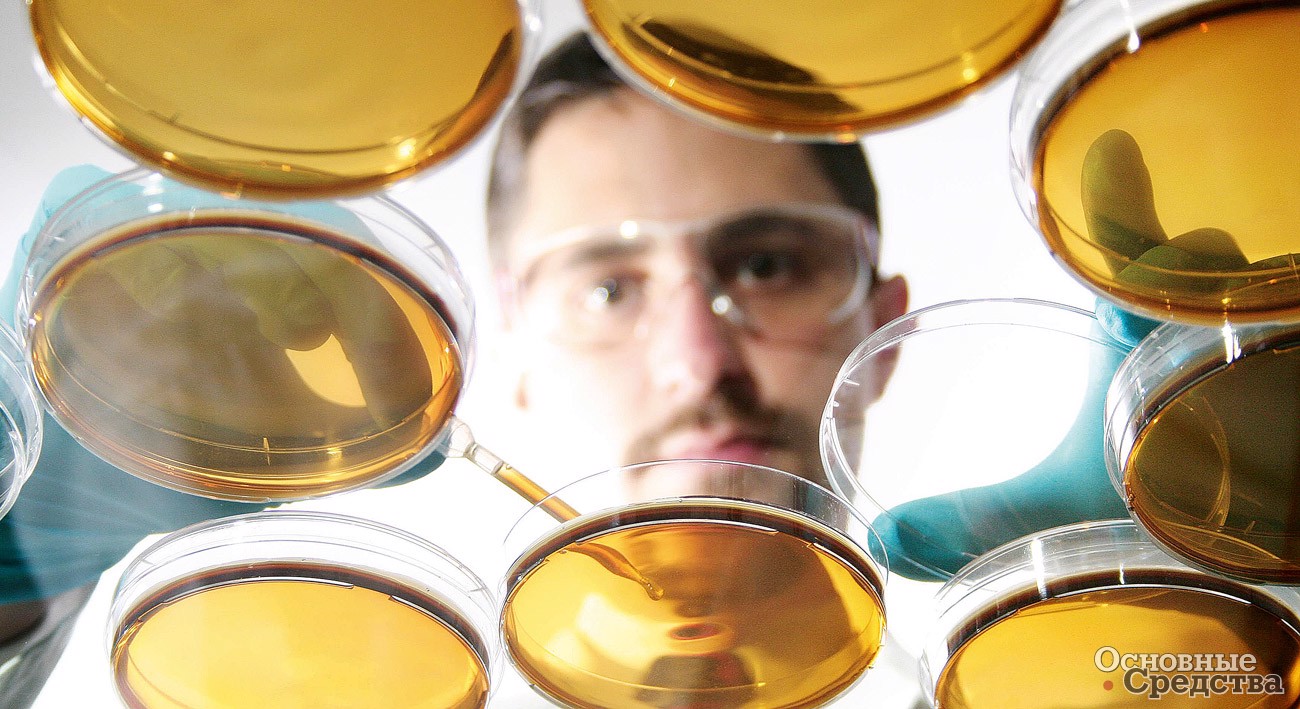

Предназначение ГУР
Нередко в кругах автомобилистов можно услышать мнение, что если гидроусилитель выйдет из строя, то это чревато аварийной ситуацией. А некоторые утверждают, что руль вообще заблокируется, и машина потеряет управление. Так может сказать только тот, кто имеет смутное представление о конструкции рулевого управления.

Да, если гидравлическая система рулевого управления выйдет из строя, это повлияет на работу автомобиля. В частности, будет намного сложнее поворачивать руль, когда автомобиль стоит, или когда он едет на малой скорости. И хрупкая девушка вряд ли справится с этой задачей.
Но в целом по-настоящему опасных и необратимых последствий не будет, даже при полном выходе из строя гидроусилителя. А на скорости отсутствие гидроусилителя будет почти незаметно.
Назначение гидроусилителя руля можно понять из названия. Этот элемент не является существенным или решающим для управления. Это только увеличивает усилие, которое водитель прикладывает к рулю.
На подавляющем большинстве не просто автомобилей, а транспортных средств в целом гидроусилитель руля играет вспомогательную роль.
Исключение составляют грузовые автомобили, у которых часто отсутствует прямая механическая связь между рулевым колесом и управляемыми колесами. Например, подобное решение было использовано при строительстве крупнейшего в мире карьерного отвала БелАЗ.
Для чего применяется смазка в ГУР
- передача мощности от насоса к распределителю и от распределителя к одной из рабочих полостей в стойке;
- смазка трущихся элементов;
- защита от коррозии;
- поддерживать тепловой баланс.
Для нормальной работы гидроусилителя необходимо масло, которое не только выполняет все вышеперечисленные функции, но и не повреждает внутренние детали ГУР.
Как известно, большинство технических жидкостей в автомобиле имеют свой ограниченный ресурс и подлежат замене через определенный срок или пробег. К таким жидкостям также относится жидкость для гидроусилителя руля.
Зачем нужно менять жидкость в ГУР, подробности неполадок — видео
Период между последовательными заменами в большинстве случаев указан в руководстве по эксплуатации автомобиля. Периоды работы можно исчислять в километрах и временных интервалах. Эти периоды составляют примерно 30-45 тысяч километров или 2-3 года.
Тут возникает закономерный вопрос: какое масло заливать в ГУР? Можно ли использовать другие жидкости? Все зависит от модели автомобиля и масла, которое было залито до этого. 
Одни гидроусилители руля рассчитаны на работу с жидкостью определенных марок, другие предполагают возможность смешивания с аналогичными составами, а третьи можно без проблем заливать практически любым маслом, предварительно промыв систему.
Преимущества и недостатки
Масла, заливаемые в гидравлику МТЗ 82, имеют свои преимущества и недостатки. К первым относятся защита деталей механизма от коррозии и износа, эффективная передача энергии, возможность работы в широком диапазоне температур и предотвращение образования налета.
При наличии в составе примесей и посторонних примесей масло может вывести машину из строя или нанести серьезный ущерб. Безопасная эксплуатация гидравлического масла возможна только после его тщательной фильтрации.

Параметры, классификация, различия автомасел для коробок переключения передач
Стоит сказать, что основой производимых сегодня трансмиссионных масел считаются синтетические, полусинтетические и минеральные воды. Разные типы трансмиссионных смазок различаются по вязкости и уровню нагрузки. Сегодня широко распространены классификации API и SAE.
Согласно спецификации SAE все расходные материалы для трансмиссии делятся на три категории вязкости.
- 70w — 85w — для зимы.
- 80w — 250w — для лета.
- 75w — 90w и 80w — 140w — для всех сезонов.
Спецификация API делит расходные материалы для трансмиссии на семь категорий в зависимости от максимальной нагрузки. Эти категории отмечены надписью «GL» и номером от 1 до 6.
Подробная информация о составе смазки и ее показателе вязкости должна быть прописана в инструкции от производителя.

Вне зависимости от производителя масла и синтетика, и минералка имеют примерно одинаковые показатели вязкости, но серьезно различаются содержащимися в них присадками.
Именно присадки делают трансмиссионные расходники такими разными и делают невозможным смешивание разных марок моторных масел. Любая компания, производящая разные смазки для коробок передач, производит их самостоятельно и не раскрывает собственный производственный процесс.
Только в экстренных случаях можно смешивать, например, минеральную воду с синтетическими веществами, при условии, что значительный недостаток автомобильного масла в коробке передач намного хуже возможного смешения.
Поэтому, если у вас нет возможности купить и залить в коробку передач свежую синтетику, можно заменить ее минеральной водой, но только как временную меру. Как можно скорее замените минеральное масло на синтетическое.
Признаки несовместимости пластичных смазок
По каким признакам можно сразу, без проведения лабораторного анализа, понять, что смешанные жиры несовместимы? Типичным проявлением несовместимости консистентной смазки является, например, сильное разбавление смазки, которое может еще больше увеличиваться при повышении температуры или усилия сдвига, или, наоборот, затвердевание смазки из-за выделения базовых масел из смешанного продукта при повышенных температурах.

Что будет, если смешать разные трансмиссионные масла?
Можно ли смешивать трансмиссионные масла? Что происходит, когда вы смешиваете различные марки и типы трансмиссионных смазок? Прежде чем ответить на эти вопросы, нужно понять, что и трансмиссионные, и моторные масла не являются однородными нефтепродуктами.

Несмотря на то, что трансмиссионные масла разных производителей могут иметь схожие характеристики, они все же существенно различаются по базе, присадкам и вязкости.
Специалисты не рекомендуют смешивать разные трансмиссионные масла, вне зависимости от схожести характеристик.
Как работают пластичные смазки
Особенность составов смазочных материалов часто является причиной несовместимости даже между двумя марками продукции одного типа.
Каждый жир содержит три ингредиента: базовое масло, загуститель (иногда называемый гелеобразователем или наполнителем) и добавки. Как правило, базовое масло составляет 80-90%, загуститель 5-30% и присадки 2-5% от общей жировой композиции.

Как сказано в энциклопедии: «Консистентные смазки — это полутвердые смазки, обладающие высокой начальной вязкостью, но при применении сдвига вязкость смазки снижается и создается смазывающий эффект, аналогичный жидкому маслу, имеющему вязкость примерно равную к вязкости базового масла смазки». Проще говоря, представьте, что загуститель — это как бы губка, которая удерживает базовое масло с присадками. Когда на слой смазки между трущимися поверхностями начинает действовать сдвигающая сила (давление и скорость деформации материала), загуститель, как усадочная губка, выделяет часть масла с присадками для выполнения смазочных функций — создания масляной пленки между трющимися поверхностями поверхности. При снятии силы сдвига загуститель вновь связывает жидкое масло.
Более точно поведение смазки технически можно описать следующим образом: ее вязкость снижается под действием сдвигающей силы при достижении сдвиговой прочности и восстанавливается при сдвигающей силе ниже предельного уровня. Это свойство называется «тиксотропией» (это способность вещества уменьшать вязкость (разжижаться) от механического воздействия и повышать вязкость (густеть) в состоянии покоя).

Можно ли смешивать масла GL-4 и GL-5?
Для автомобилей с АКПП требуется смазка API GL-4, для механических приводов и коробок передач API GL-5. Масло API GL-4+, API GL-4/5 применяется для переднеприводных автомобилей. Он предназначен для работы с интегральным дифференциалом. Заменять GL-4 на GL-5 и наоборот нельзя, это приведет к быстрому износу деталей.
Какое масло нужно заливать в гидравлику?
Тип рекомендуемого масла обычно указывается в кабине на специальных информационных табличках или непосредственно на баке гидросистемы, рядом с заливной горловиной. На современном импортном оборудовании сегодня чаще всего рекомендуется к применению масло с высоким индексом класса HVLP.
Можно ли смешивать масло 10W40 и 10W40 разных производителей?
Каждая группа имеет разный состав, даже у одного производителя линейка масел может сильно различаться. Краткий ответ на вопрос, можно ли смешивать масла разных производителей, крайне нежелателен, но допустим.
Синтетические и полусинтетические гидравлические масла
Гидравлическое минеральное масло не всегда можно использовать в некоторых системах из-за его низких эксплуатационных характеристик. Синтетические и полусинтетические продукты обладают не только высокими вязкостно-температурными свойствами, но и большей огнестойкостью и взрывопожаробезопасностью. Такие масла применяются в горнодобывающем оборудовании, металлургии, микрокриогенном оборудовании и других областях, где требуется повышенный уровень безопасности.
Большинство синтетических продуктов имеют высокую температуру самовоспламенения и не поддерживают горение, в отличие от минеральных гидравлических масел.
Обладая низкой температурой застывания, синтетические смазки можно использовать в авиационных системах и в арктических условиях.
Но цена гидравлического масла на синтетической основе намного выше, чем на минеральные продукты.
Консистенция и прокачиваемость
Вид и доля содержания загустителя в общем объеме смазки определяет также ее «консистенцию» (механическую стабильность), т.е способность сопротивляться деформации под действием силы сдвига, оставаться на месте и не выдавливаться из полость.
Национальный институт смазок (NLGI, США) разработал классификацию смазок из 9 классов «консистенции» от 000 до 6, которая принята в качестве международной и соответствует европейскому стандарту для смазочных материалов DIN 51 818. Чем выше класс консистенции, чем тверже смазка. Класс определяется глубиной проникновения эталонного конуса в смазку. В строительной технике часто применяют смазки класса консистенции 0, 1 и 2. В России действует ГОСТ-5346, определяющий характеристику «пенепроницаемость при 25°С», которая также является мерой консистенции смазки.
Еще одной характеристикой смазки, зависящей от вязкости базового масла и свойств загустителя, является «прокачиваемость» (динамическая вязкость), т.е способность смазки течь по каналам централизованной автоматической системы смазки при различных температурах, диаметры и длины каналов. Прокачиваемость измеряют с помощью такого прибора, как вентметр Линкольна.

Лабораторные анализы на совместимость пластичных смазок
В специализированных химических лабораториях при испытании смазок на совместимость обычно делают анализы на консистенцию NLGI и температуру каплепадения: сначала для каждой из исходных смазок, затем для смеси смазок в соотношении 90/10, причем в обоих вариантах, и для смеси 50/50. Если смесь получает более низкий класс консистенции по сравнению с исходными смазками, такие смазки несовместимы. Это же касается и случая, когда температура каплепадения смеси заметно ниже допустимого предела значений для обеих оригинальных смазок. Если изменения консистенции и температуры каплепадения остаются в пределах допусков от значений исходных смазочных материалов, их можно считать «частично соответствующими/сомнительными/требующими испытаний». Также при оценке совместимости новой смазки и старой, уже работающей в агрегате, образцы новой и старой смазок, взятые из агрегата, смешивают. Смысл этого анализа в том, что в процессе эксплуатации в смазку могут попасть загрязняющие вещества, которые отрицательно скажутся на совместимости смазок, или условия эксплуатации могут сделать смесь несовместимой при определенных конкретных условиях эксплуатации.
Можно ли смешивать гидравлические масла разных производителей?
Нельзя смешивать масла разных производителей с разными свойствами. Индекс вязкости должен соответствовать. Но можно заменить одного производителя на другого.
Чем отличается гидравлическое масло 32 от 46?
Отличие продуктов заключается в их индексе вязкости. Простым и доступным языком масло с индексом 32 можно назвать маловязким по сравнению с продуктом с индексом 46. Также артикулы имеют небольшую разницу по температуре застывания и максимальной верхней температуре.
Какие бывают мнения
На самом деле лить или не лить – вопрос достаточно деликатный и ставит в тупик даже опытных автомобилистов. Причем мнения по этому поводу кардинально расходятся. Одни категорически не советуют смешивать, другие говорят, что если смешать, ничего страшного не произойдет. Но так ли это и что будет, если смешать все одинаково?
Все существующие мнения можно разделить на три группы:
- Смешивание моторных масел не допускается. Производители смазочных материалов используют разные нефтепродукты, а главное, разные присадки. Есть добавки, которые могут вступать в конфликт друг с другом. В результате смесь может вспениться или выпасть в осадок. А потом — капитальный ремонт двигателя.
- Допускается смешивание масел. Причем, это может быть что угодно, т.е можно, например, в Shell 5w30 синтетику добавить минералку Castrol 15w40 и все будет хорошо. Что я могу сказать? Такие эксперименты лучше не проводить — ваш двигатель это точно не оценит.
- Смешивать масла можно, но только соблюдать определенные правила. Это гораздо ближе к истине. Почему — скоро узнаем.
Но это в основном теория. На практике бывает иначе, водитель в безвыходной ситуации рискует, смешивает «несмешивающиеся» жидкости и двигатель работает нормально. А можно купить хорошее масло и иметь проблемы с машиной в прицепе. Поэтому первое правило – нельзя экономить на смазочной жидкости.
Что говорят производители

Кажется — кто лучше производителей ГСМ знает, можно ли смешивать моторные масла. А вот концерны, производящие смазочные материалы, предпочитают отмалчиваться.
Почему это происходит? Тут все просто — ну кто посоветует покупать у конкурентов? Наоборот, каждый производитель говорит, что его продукция самая лучшая, технологичная, эффективная и так далее, подразумевая при этом, что все остальные марки намного уступают.
Как выбрать масло для ГУР
Как бы банально это не казалось, масло в ГУР желательно заливать только тем маслом, которое рекомендовано заводом-изготовителем. Здесь нет универсальных методов.
Гидравлические масла обладают несколькими основными свойствами, определяющими область их применения. Одним из самых важных является тип основания. Основным фактором, учитываемым при выборе, является основа жидкости для гидроусилителя.

Подборка жидкостей, используемых при замене масла в ГУР
Сегодня в этой области смазочных материалов распространены два типа основ: минеральные и синтетические. Полусинтетические вещества тоже встречаются, но гораздо реже.
Жидкость для гидроусилителя руля на минеральной основе имеет как преимущества, так и недостатки. В этом случае традиционные представления, присущие моторным смазкам, не работают. Специфика использования минерального моторного масла заключается в его щадящем воздействии на резиновые уплотнители.
Однако здесь следует сказать, что многие современные автомобили выпускаются с расчетом на использование синтетических материалов в гидравлической системе рулевого управления. Их манжеты и уплотнительная резина не вступают в химическую реакцию с активными компонентами синтетических жидкостей.
Минеральные жидкости для гидроусилителя руля обладают несколько лучшими смазывающими свойствами. Однако их температурный диапазон ниже. Если автомобиль эксплуатируется в умеренных широтах, где нет сильных морозов и сильной жары, вполне можно использовать минеральное масло. Хотя конструкция рейки и насоса ГУР допускает использование синтетики.
Синтетические жидкости для ГУР имеют более стабильные свойства в широком диапазоне температур и более длительный ресурс по сравнению с минеральной водой.
Цветовые отличия жидкости и ее характеристики
Но не забывайте, что если синтетические масла не предназначены для использования в той или иной системе управления, их применять не следует. Среди автомобилистов принято классифицировать жидкости по цвету.
Подавляющее большинство гидравлических масел бывает трех оттенков:
- Красный.
- Желтый.
- Зеленый.
Красный цвет характерен для жидкостей, выпускаемых под маркой Dexron. Это высококачественные минеральные масла, широко используемые в японских автомобилях. Этот же бренд выпускает и жидкость ATF, используемую в автоматических коробках передач.

жидкость ГУР красная
Желтый цвет присущ европейским автомобилям. В частности, в этот цвет окрашивают фирменные масла Мерседес. Есть много компаний, которые производят желтые составы. Часто они идут под маркировкой PSF после указания производителя и заводской маркировки. Основа этих жидкостей минеральная. Небольшие различия между производителями кроются в добавках.

Масло с желтым оттенком
Зеленые масла могут быть как минеральными, так и синтетическими. Например, обычное масло для гидроусилителя руля, такое как Pentosin, является минеральным. Но есть зеленые жидкости, которые выпускаются под маркой авто. Они являются узкоспециализированными и предназначены для использования в определенных марках автомобилей. Например, Peugeot, Citroen, GM и некоторые другие производят свои жидкости.

зеленое масло ГУР
Ответов на вопрос, какую жидкость заливать в ГУР, может быть много. Самое правильное решение – лить масло, рекомендованное производителем. Но можно и вполне успешно подобрать аналоги.
Мы следим за стабильностью масел!
Успешно развиваясь на рынке с 2001 года, ООО «Нефтепродукт», являющееся крупнейшим производителем автомобильных масел, гарантирует, что продукт имеет высочайшее качество и полностью соответствует всем необходимым характеристикам и инструкциям.
Под торговой маркой «Оптимал» выпускается гидравлическое масло с высочайшей химической и окислительной стабильностью. Следовательно, он работает гораздо дольше в диапазоне температурных режимов, без отложений и шлама.
Известно, что гидравлическая система содержит элементы из сплавов и металлов. Поэтому из-за действия кислот и воды при окислении масел возможны коррозионные процессы. Чтобы минимизировать эти процессы, производители добавляют в жидкость марки Оптимал специальные ингибиторы и антикоррозийные присадки.
Можно ли смешивать масло Вмгз?
Масло ВМГЗ можно использовать и зимой, но так как оно изготовлено для районов Крайнего Севера, где техника работает на вечной мерзлоте 10-11 месяцев в году, советуем не использовать его в нашем регионе, так как это масло заметно дороже индустриальных масел, его нельзя смешивать с другими маслами в гидросистеме, оно …
Вероятные последствия перемешивания
Многие автолюбители, столкнувшись с необходимостью доливки количества смазки в МКПП (МКПП), рассуждают банально – коробка передач не испытывает серьезных нагрузок, как двигатель, поэтому особых требований к доливке объема нет автомобильного масла”.
Неопытный водитель считает, что можно не беспокоиться о возможных последствиях смешивания разных нефтепродуктов. Часто такой подход оказывается наиболее практичным, поскольку производители товаров народного потребления устанавливают разные цены на свою продукцию.
желание сэкономить может привести к печальным последствиям, вплоть до необходимости капитального ремонта автомобиля. Это связано с химическими реакциями, которые обязательно начнутся, если смешать минеральное масло с синтетическим.
Появится особый осадок в виде белых хлопьев. Коробка передач забьется, в том числе и масляный фильтр. Его детали будут подвергаться деформации и сильному износу.

Работники автосервиса говорят, что чаще всего коробка передач выходит из строя из-за залитой в нее смешанной смазки (минеральное масло плюс синтетика). Когда водители мешают моторным маслам, они надеются получить полусинтетический продукт. Конечно, это невозможно.
Поначалу износ коробки передач может быть не очень заметен. Однако постепенно вы начнете замечать, что режимы чередуются не так плавно, как раньше. В результате износ деталей значительно увеличился.
Таковы негативные последствия вождения автомобиля, когда в коробку передач заливается смешанная масляная жидкость.
Почему бывают несовместимы присадки
В целом присадки выполняют три основные функции: улучшают благоприятные свойства и нейтрализуют нежелательные свойства базового масла, а также создают новые свойства, которых не было у базового масла. Пакет присадок специально подбирается под конкретное базовое масло, благодаря этому базовое масло приобретает набор свойств, необходимых для выполнения различных смазочных задач. Даже если базовые масла двух смазочных материалов совместимы, содержащиеся в них присадки могут быть несовместимы. Если вы переходите со смазочного материала одной марки на смазочный материал того же типа другого производителя, они могут быть несовместимы из-за различных пакетов присадок. В основном несовместимость присадок выражается в том, что они вступают в химические реакции друг с другом и в результате разрушаются и нейтрализуются. Это может привести к потере или изменению свойств, которые присадки придали маслу, а также к образованию нежелательных побочных продуктов реакции.
Можно ли заливать дизельное масло в гидравлику?
можно ли использовать дизельное масло в гидравлике? Теоретически можно наливать воду. Просто это не будет работать долго. Из-за отсутствия смазки трущихся частей.
Можно ли долить масло в коробку другой марки?
То есть, несмотря на схожие свойства масел, они все же разные и смешивать их НЕЛЬЗЯ! Простыми словами, нельзя заливать масло производителя, например, того же Castrol, например, Mobil. Как и моторные масла, несмотря на схожие свойства, они все же могут быть разными.
Примеры из практики
«Мы подозреваем, что небольшое количество гидравлического масла на основе эфира фосфорной кислоты, предназначенного для электрогидравлической системы управления погрузчика, было по ошибке залито в емкость с синтетическим маслом на основе ПАО. Как проверить, не попало ли гидравлическое масло в синтетическое масло»?
Для смазочных материалов, имеющих совершенно разные по химическому составу базовые масла, наиболее простым способом обычно является анализ с помощью инфракрасной спектроскопии с преобразованием Фурье (FTIR-спектроскопия, ИК-спектроскопия). Анализ инфракрасных спектров позволяет обнаружить в пробе масла функциональные группы (структурные фрагменты органических молекул, определяющие их химические свойства), иными словами, определить вещества, входящие в состав этого смазочного материала, а также такие примеси, как вода, топливо и этиленгликоль (хладагент).
Следует уделить внимание анализу образца чистого масла ПАО, чистого масла на основе эфира фосфорной кислоты и предполагаемого смешанного продукта. Признаки загрязнения будет нетрудно идентифицировать: если синтетическое масло на основе ПАО загрязнено смазкой на основе эфира фосфорной кислоты, спектрограмма покажет «пик» в определенном диапазоне длин волн. Поскольку чистое масло на основе ПАО не может содержать эфир фосфорной кислоты, значит, следы этого вещества могли попасть в масло только в результате загрязнения. Большинство специализированных промышленных лабораторий способны выполнить такой анализ.
Технология гидрокрекинга
Масла производятся не только на синтетической и минеральной основе, но и на гидрокрекинге. Такие рабочие жидкости обладают лучшими параметрами и свойствами за счет применяемой сложной технологии очистки. Гидрокрекинговые масла практически не отличаются от синтетических, поэтому производители обычно не указывают способ производства. Это не влияет на качество. Масла применяются в многоклапанных двигателях, оборудованных гидрокомпенсаторами.
Применение гидравлического масла
Этот тип жидкости относится к легкорасходуемым материалам. Для поддержания работоспособности гидравлической системы необходимо обновлять смазочную жидкость через 1000 часов работы или один раз в год. Важно знать, как правильно заливать гидравлическое масло:
- Откачивают отходы из системы с помощью подручных средств или специального оборудования.
- Очистите гидробак от загрязнений.
- Закачивается свежая порция, уровень которой определяют через смотровое окошко или щупом.
- Запустите насос, чтобы запустить циркуляцию масла по системе.
- При необходимости долейте жидкость до нужной отметки.
Взаимозаменяемость и смешиваемость
По вопросу взаимозаменяемости и смешиваемости жидкостей ГУР на сегодняшний день существует множество мнений. Более того, даже мнения экспертов расходятся по некоторым аспектам этого вопроса. Какая жидкость заливается в конкретный автомобиль, что можно использовать в качестве аналога и как предотвратить негативные последствия?

Общие рекомендации:
- необходимо использовать масло с тем типом основы, который применялся ранее (минеральное или синтетическое);
- при смешивании не рекомендуется использовать жидкости разных цветов, но это и не запрещено категорически;
- не стоит заливать ГУР узкоспециализированными жидкостями, предназначенными для других марок автомобилей, даже при совпадении типа субстрата.
Если планируется полная замена жидкости, ее можно менять с учетом фундамента. Например, зеленое масло на минеральной основе можно полностью заменить желтым маслом на той же основе.
Если вам нужно просто долить жидкость в бак, попробуйте подобрать здесь цвет и марку. Для кратковременных растворов можно смешивать жидкости разных цветов. Но при условии, что их составы схожи.
Что будет если залить трансмиссионное масло в двигатель?
Смешанное с моторным маслом масло, предназначенное для коробок передач, просто начнет гореть, образуя налет, который забьет фильтр, микроскопические масляные каналы и патрубки.
Нюансы
Для обеспечения бесперебойной работы гидравлики смазка должна соответствовать определенным стандартам:
- На территории России принят ГОСТ, соответствующий международным стандартам. Гидравлические жидкости соответствуют номеру 17479.3-85, состоящему из трех групп знаков, обозначающих область применения, наименование и класс вязкости.
- Гидравлический механизм работает при высоких температурах, поэтому температура вспышки гидравлического масла должна быть высокой, в отличие от точки замерзания — очень низкой.
- Смазки проходят тщательную фильтрацию, но на фильтрующем элементе накапливаются полимерные добавки, которые добавляются в состав для повышения показателя вязкости. В аварийной ситуации об этом сигнализирует датчик давления. При замене гидравлического масла необходимо проверить состояние фильтра и при необходимости заменить его.
- Качество и состояние уплотнений необходимо регулярно проверять, чтобы предотвратить утечку. Материал, из которого они изготовлены, должен быть совместим с используемым маслом. Рекомендуется выбирать фирменные уплотнения, предназначенные для конкретной гидравлики.
- Масла, предназначенные для разных гидравлических систем, нельзя смешивать.

Загустители
Почему существует много типов загустителей? Потому что разные загустители придают жирам разные свойства. Кальциевые мыла, например, обеспечивают отличную водостойкость (способность сопротивляться вымыванию водой), такая смазка не испортится при использовании в условиях, когда на нее постоянно воздействует вода. Однако температура каплепадения смазочных материалов на основе кальциевых мыл (т.е температура плавления) очень низкая. Обычно смазке стараются придать такую термостойкость, чтобы в диапазоне рабочих температур она имела запас 40-55°С до температуры плавления. Литиевое комплексное мыло придает смазке жаростойкость, но водостойкость такой смазки хоть и неплохая, но не отличная.
Наиболее часто используемым неметаллическим загустителем является полимочевина. Этот термин, как имя нарицательное, относится ко всем неметаллическим загустителям. Такие вещества используются, например, в смазочных материалах, которые должны обладать высокими антиокислительными свойствами (стойкостью к старению) и иметь длительный срок службы. Состав и содержание загустителей во многом определяют цену жира.
Замена нескольких пластичных смазок одним аналогом
Если автопарк состоит из нескольких автомобилей, организовать правильное использование смазки в таких условиях очень сложно. А стремление в точности следовать всем рекомендациям производителей оборудования может привести к тому, что компании придется хранить на складе большое количество тары смазочных материалов разного качества.
Как избежать ошибок при заливке смазочных материалов в такой ситуации? Некоторые специалисты предлагают использовать заливные форсунки и пресс-масленки, окрашенные в разные цвета в зависимости от марки и типа смазки. Другие предлагают использовать различные типы заправочных фитингов и пресс-масленок, чтобы подходили только определенные заправочные сопла.
Но есть и другой, более экономичный вариант: сократить количество используемых смазок, заменив несколько совместимых смазок на одну, без ущерба для качества смазки узлов машины. Усложняет это решение отсутствие рекомендаций от некоторых дилеров оборудования, которые на удивление не разбираются в смазочных материалах для оборудования, которое они продают и обслуживают. Производители оборудования часто предоставляют мало информации о совместимости и характеристиках смазок.
Тем, кто сталкивается с этой проблемой, мы рекомендуем обратиться к специалистам по смазочным материалам, которые хорошо разбираются в рецептурах, свойствах и применении смазок. При принятии решения о замене нескольких марок смазки единым аналогом необходимо собрать как можно больше информации по этому вопросу: запросить характеристики этих смазок у производителя нефтепереработки и сравнить предъявляемые требования к свойствам смазок различными машинами, входящими в состав этого автопарка.

Как отличить моторное масло от гидравлического?
Тест состоит из оценки поведения капли масла в воде. Если уронить перевод в воду, он сразу растечется тонким слоем. Если используется моторное масло, капля сохранит свою округлую форму и будет плавать на поверхности.
Отличия синтетических смазочных материалов от минеральных
Синтетические смазочные материалы, в отличие от обычных минеральных масел, не производятся из нефти. Их синтезируют из природного газа и других материалов. Например, полиальфаолефины (ПАО), наиболее распространенные синтетические базовые масла, синтезируются путем полимеризации молекул этилена и децена (которые в основном получают из природного газа). В отличие от минеральных масел, которые могут содержать миллионы различных молекул и молекулярных структур, размер и форма молекул одного типа синтетического масла гораздо более однородны и стабильны. Благодаря этому свойства смазки более стабильны, а жизненный цикл более предсказуем.
В последнее время возникла некоторая путаница в отношении использования термина «синтетические смазочные материалы». Несколько нефтехимических компаний разработали процесс каталитического превращения основных компонентов сырой нефти при высоком давлении и температуре в присутствии водорода (гидрокрекинг) в минеральные смазочные материалы очень высокого качества. Эти смазочные материалы группы API III настолько глубоко очищены, что их характеристики почти соответствуют синтетическим смазочным материалам группы IV. В Соединенных Штатах суд поддержал право называть эти смазочные материалы «синтетическими», когда производители настоящих синтетических смазочных материалов группы IV подали в суд на производителей смазочных материалов группы III за «ложную рекламу». Хотя базовые масла группы III изготавливаются из сырой нефти, теперь их можно по закону называть синтетическими в маркетинговых целях.

Можно ли смешивать масло ATF разных производителей?
Можно смешивать разные типы ATF, но в этом случае уже есть определенная, хоть и очень маленькая, вероятность поломки, поэтому от смешивания минерального и синтетического масел лучше воздержаться.
В чем разница между гидравлическим и трансмиссионным маслом?
Трансмиссионные масла работают при высоких скоростях скольжения, давлениях и широком диапазоне температур. Гидравлические масла (рабочие жидкости для гидравлических систем) делятся на нефтяные, синтетические и водно-гликолевые.
Какое масло лить в гидравлику манипулятора?
В инструкции по эксплуатации HIAB CMU указаны рекомендуемые гидравлические масла, вязкость ISO VG 32, класс HLP (HM), гидравлическое масло — Total Azolla ZS 32 может быть рекомендовано как прямой аналог, также для улучшения работы при отрицательных температурах может быть рекомендовано для круглогодичного использования — …
Особенности гидравлических масел
Какое масло заливать в гидравлику? Смазки для механизмов следует выбирать с учетом температурных и вязкостных характеристик. Использование слишком вязкого масла может привести к снижению КПД и мощности системы, что приведет к увеличению нагрузки на оборудование. Плотность используемого масла напрямую зависит от температурного режима, в котором работает гидросистема, этот критерий указывается в гидравлическом паспорте и должен учитываться при выборе смазки.
Масло подбирается в зависимости от сезона эксплуатации. В холодное время года используется зимнее гидравлическое масло, обладающее нужными свойствами.
Не менее важную роль при выборе смазочной жидкости играют антикоррозионные и антиокислительные свойства. Эти свойства влияют на коррозионный износ механизма и образование отложений на стенках.
Чем отличается гидравлическое масло 32 от 46?
Отличие продуктов заключается в их индексе вязкости. Простым и доступным языком масло с индексом 32 можно назвать маловязким по сравнению с продуктом с индексом 46. Также артикулы имеют небольшую разницу по температуре застывания и максимальной верхней температуре.
Почему нельзя смешивать гидравлические масла?
Замена гидравлических масел и их смешивание
В то же время масла на основе гликоля могут быть несовместимы с другими маслами на основе гликоля, так как часть сложных эфиров теряется при смешивании. Смешивание разных масел может быть вредным для окружающей среды, а также может значительно снизить эффективность масла.
Совместимость синтетических масел
«Синтетические» — это общее название смазочных материалов, содержащих синтетические вещества. Синтетические смазки могут иметь совершенно разные эксплуатационные характеристики и быть совершенно несовместимыми.
Какая рабочая температура гидравлического масла?
Рабочая температура масла в гидравлической системе составляет ок. 80°С. При перегреве машины ее производительность снижается, она перестает реагировать на действия оператора, на панели появляется индикация о перегреве масла.
Советы и рекомендации
Итак, как видите, смешивать трансмиссионные масла крайне нежелательно, особенно если речь идет об автоматических коробках передач. Единственным исключением можно считать случаи, когда критическое падение уровня масла в коробке передач происходило прямо в дороге.
Косвенным признаком того, что масло в коробке передач нужно заменить как можно скорее, также является шум или жужжание при работе коробки передач. Это свидетельствует о том, что в коробку залито некачественное или неподходящее масло. При этом замена смазки часто решает эту проблему.
Вязкость
Вязкость гидравлического масла зависит от типа установленного насоса и делится на три категории:
- Оптимальный.
- Минимум.
- Максимум.
Минимальная вязкость наиболее важна, когда гидравлическая система наиболее горячая. Это свойство не позволяет смазке выходить через уплотнения. Однако максимальный уровень вязкости важен при низких температурах окружающей среды. Этот показатель необходим для прокачки смазки по системе. При выборе масла необходимо учитывать технические характеристики трубопровода и мощность насоса. Оптимальная вязкость сочетает в себе все основные требования и позволяет свести потери к минимуму. Не смешивайте масла разной вязкости.
- https://prosmazku.ru/zamena/zhidkost-dlya-gidrousilitelya-rulya
- https://FB.ru/article/423151/maslo-dlya-gidravliki-kakoe-maslo-zalivat-v-gidravliku
- https://evakuatorinfo.ru/mozhno-li-smeshivat-maslo-v-reduktore-zadnego-mosta/
- https://os1.ru/article/14994-sovmestimost-smazochnyh-materialov-raznyh-sortov-zapravlyay-no-proveryay
- https://avtograf70.ru/zapchasti/mozhno-li-smeshivat-gidravlicheskoe-maslo.html
- https://chinzap.ru/diagnostika-i-obsluzhivanie/mozhno-li-smeshivat-gidravlicheskie-masla-raznyh-proizvoditelej.html
- https://centr-dostavki.ru/mozhno-li-smeshivat-gidravlicheskie-masla-raznyh-proizvoditelej.html
- https://mzoc.ru/uhod-za-avtomobilem/mozhno-li-smeshivat-gidravlicheskie-masla-raznoj-vyazkosti.html